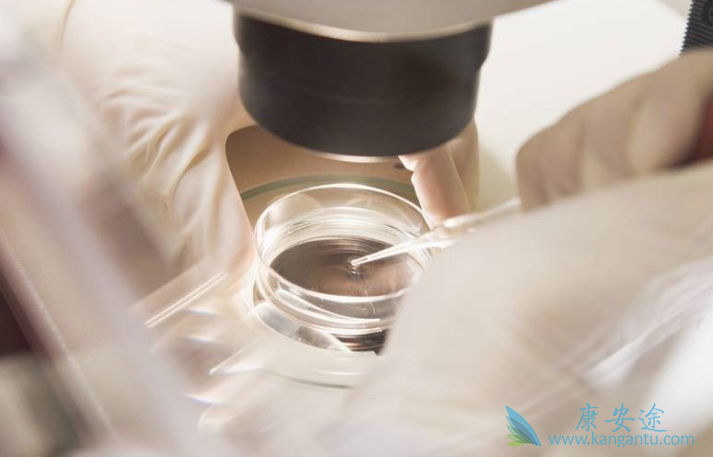
泰国试管婴儿费用 泰国试管婴儿费用

国内很多去泰国做试管婴儿的不孕不育患者,到了泰国人生地不熟,语言不通相当麻烦,所以现在很多人去做泰国试管婴儿的都会选择服务医疗机构,面对医疗机构的选择,很多人犯难。很多人了解到费用少到1、2万,多到十几万不等,于是开始纠结,选择1-2万的省钱,但是心里不禁嘀咕靠不靠谱啊,会不会被骗啊,选择十几万的又觉得费用太高,那么究竟是怎么回事呢?同样是去做泰国试管婴儿费用差距如此之大呢?其实面对低价诱惑的时候你就要小心了。
一些中介说的1-2万去泰国做试管婴儿是不可能的,100%是骗人的。去做泰国试管婴儿费用3-6万,这个费用只是把你送到泰国,找一些兼职翻译,其他的住宿、一日三餐等都是不管的,医疗费用也是需要你自己交给医院的;初到国外什么都不懂会有很多不便,如果这样的话还不如自己去泰国做试管婴儿,自己找住宿翻译等;泰国试管婴儿费用在16-18万左右的,泰国试管婴儿费用包括医疗费用和生活服务费用,医疗费用一般8-10万,服务费用则是可以按照自身要求制定。服务包括签证,专车接送,生活翻译,医疗翻译,保姆,星级酒店及其他住宿等等。因此,可以肯定一点的是,费用越低相对应的服务质量一定很差,我们既然选择服务好的医疗机构去泰国做试管婴儿,就是希望能少操点心,把心思全放在做试管上边,放松心态,把身体心理素质调整到最佳,为一次就成功做好充足的准备;
如果考虑自己去的话,不仅衣食住行要考虑,每个阶段医院收取费用也要自己去操心,这样就会把更多的心思花在跟试管不相干的事情上,那么整个试管旅程也是比较劳心费神的。国内因为看诊和服务的局限性,从递交资料到看诊到试管排期,进周,促排,取卵,移植,验孕都是一个很艰辛的过程,全部流程2-3个月。尤其是女性在心理,身体和精神上都是高度紧张,备受煎熬的过程。而泰国三代试管婴儿全部流程是28天左右,全程都是轻松的状态,医生会根据每一对夫妻制定适合他们身体状况的试管方案,让每一对夫妻在轻松愉快的心情下达成好孕心愿。要知道,试管成功率除了和夫妻双方的身体情况、医院医生的技术有关外,还与夫妻双方精神状态有很大关系。选择服务机构必然是考虑因素,但是想下试管的最终目的是希望成功怀孕,所以各方面要综合考虑。
















请简单描述您的疾病情况,我们会有专业的医学博士免费为您解答问题(24小时内进行电话回访)